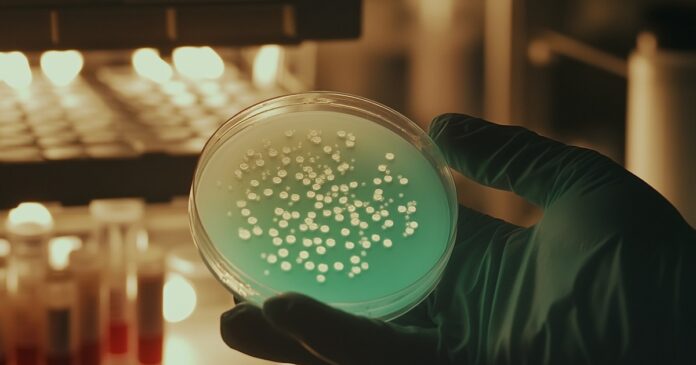

El desarrollo de un sistema de secuenciación rápida de ADN en el Reino Unido representa un avance crucial en la lucha contra las infecciones bacterianas y la propagación de superbacterias resistentes a los antibióticos. La iniciativa, impulsada por la Agencia Reguladora de Medicamentos y Productos Sanitarios (MHRA) y el Servicio Nacional de Salud (NHS) del Reino Unido, permite detectar infecciones de manera más rápida y precisa, lo que mejora el tratamiento de los pacientes y reduce los riesgos asociados con el uso indiscriminado de antibióticos.
En la actualidad, los laboratorios hospitalarios pueden tardar hasta siete días en identificar el tipo exacto de bacteria que causa una infección, y en algunos casos, el diagnóstico definitivo puede demorar hasta ocho semanas. Este retraso obliga a los médicos a administrar antibióticos de amplio espectro, que pueden no ser efectivos, provocar efectos secundarios y contribuir a la resistencia bacteriana.
“Cuando alguien ingresa en el hospital con una infección grave, cada hora cuenta”, explicó la Dra. Chrysi Sergaki, jefa de microbioma en la MHRA a The Guardian. “En lugar de esperar días o incluso semanas para identificar exactamente qué está provocando su infección, los hospitales ahora pueden obtener respuestas en 48 horas”, dijo.
La nueva tecnología reduce el tiempo de diagnóstico de semanas a 48 horas (Imagen Ilustrativa Infobae)
Limitaciones de los métodos tradicionales de diagnóstico.
Hasta ahora, la detección de infecciones bacterianas en los hospitales depende del cultivo de muestras en laboratorio. Sin embargo, este método presenta limitaciones. En primer lugar, el proceso puede tardar varios días, lo que retrasa la administración de un tratamiento específico. En segundo lugar, la sensibilidad de los cultivos es limitada, especialmente en pacientes que ya han recibido antibióticos.
“Dado que el uso de antibióticos de amplio espectro puede reducir la producción bacteriana en un paciente, estos cultivos a menudo arrojan resultados negativos”, explicó Ian Butler, científico clínico principal en microbiología médica en Barts. “Esto dificulta la obtención de un diagnóstico definitivo y obliga a los pacientes a recibir una terapia antibiótica prolongada de amplio espectro”.
El uso excesivo de antibióticos sin un diagnóstico preciso afecta la recuperación del paciente y contribuye al desarrollo de resistencia bacteriana. En este contexto, las superbacterias se han convertido en una de las principales amenazas para la salud pública global.
Expertos advierten que la resistencia bacteriana es una amenaza global (Olaug Elisabeth Torheim Bergum y Amanda Holstad Singleton)
Cómo funciona la secuenciación rápida de ADN
La nueva tecnología de secuenciación de ADN desarrollada en el Reino Unido ofrece una innovadora solución al problema, según los científicos a cargo. Este proceso consiste en leer el código genético de las bacterias presentes en una muestra clínica, lo que permite identificar de manera precisa la especie bacteriana y determinar a qué antibióticos es resistente.
El procedimiento es similar a descifrar un “manual de instrucciones” que indica cómo funciona cada bacteria. A partir de esta información, los médicos pueden seleccionar el antibiótico más efectivo para tratar la infección en lugar de recurrir a tratamientos genéricos de amplio espectro.
“Al identificar las bacterias de forma rápida y precisa, especialmente en pacientes que han recibido tratamiento con antibióticos, podemos administrar antes los antibióticos adecuados y específicos”, explicó Butler. “Esto garantiza una recuperación mucho más rápida y reduce el riesgo de efectos secundarios y complicaciones asociadas con los antibióticos de amplio espectro”.
El sistema de secuenciación rápida de ADN ya fue probado con éxito en 2.000 pacientes del NHS británico, donde demostró su eficacia para proporcionar diagnósticos más rápidos y permitir tratamientos más específicos. Según los expertos, esta innovación podría convertirse en una práctica rutinaria en los hospitales, en primero lugar del Reino Unido.
La herramienta permitiría usar menos antibióticos de amplio espectro y usar tratamientos más precisos (Andina)
El principal beneficio es la reducción del tiempo necesario para identificar la infección y determinar el tratamiento adecuado. Mientras que los métodos tradicionales pueden tardar semanas, la secuenciación de ADN ofrece resultados en solo 48 horas. Esto se traduce en una recuperación más rápida de los pacientes, una menor incidencia de complicaciones como la sepsis y una reducción del riesgo de transmisión de infecciones dentro de los hospitales.
Además, la implementación de este sistema tiene el potencial de optimizar el uso de antibióticos a nivel hospitalario, y evitar la administración innecesaria de esos fármacos de amplio espectro, a la vez que se reduce el desarrollo de superbacterias.
La resistencia a los antibióticos es un problema de salud mundial
La Organización Mundial de la Salud (OMS) ha advertido que la resistencia a los antibióticos es una de las mayores amenazas para la salud pública global. El surgimiento de bacterias resistentes plantea un desafío crítico para la medicina, ya que reduce las opciones terapéuticas disponibles y puede generar infecciones difíciles de tratar. Si no se toman medidas urgentes, se corre el riesgo de que enfermedades comunes vuelvan a ser potencialmente mortales debido a la falta de antibióticos.
Desde hace décadas, los expertos han señalado que la administración inadecuada de antibióticos es un factor clave en el aumento de superbacterias. La optimización en la selección, la dosis y la duración del tratamiento es una de las estrategias recomendadas para garantizar el mejor resultado terapéutico con el menor impacto en la resistencia bacteriana.
Investigadores británicos prueban con éxito un sistema de secuenciación rápida (EFE/Luis Ángel González)
Según precisa la OMS, “la resistencia a los antimicrobianos se produce cuando bacterias, virus, hongos y parásitos cambian a lo largo del tiempo y dejan de responder a los medicamentos, lo que dificulta el tratamiento de infecciones y aumenta el riesgo de propagación de enfermedades, enfermedades graves y muerte. Consiguientemente, los medicamentos se vuelven ineficaces y las infecciones persisten en el cuerpo, lo que aumenta el riesgo de propagación a otras personas”.
Los antimicrobianos, que incluye a los antibióticos, antivirales, antifúngicos y antiparasitarios, “son medicamentos utilizados para prevenir y tratar infecciones en seres humanos, animales y plantas. En ocasiones se llama supermicrobios a los microorganismos que desarrollan resistencia a los antimicrobianos”, agregó el organismo multilateral de salud.
Ante este panorama, la secuenciación rápida de ADN se presenta como una herramienta con el potencial de transformar el diagnóstico y tratamiento de infecciones bacterianas en todo el mundo. Al proporcionar información precisa en un corto período de tiempo, esta tecnología podría mejorar la recuperación de los pacientes y contribuir a frenar el avance de las superbacterias y proteger la salud pública a largo plazo.
Fuente: https://www.infobae.com/america/